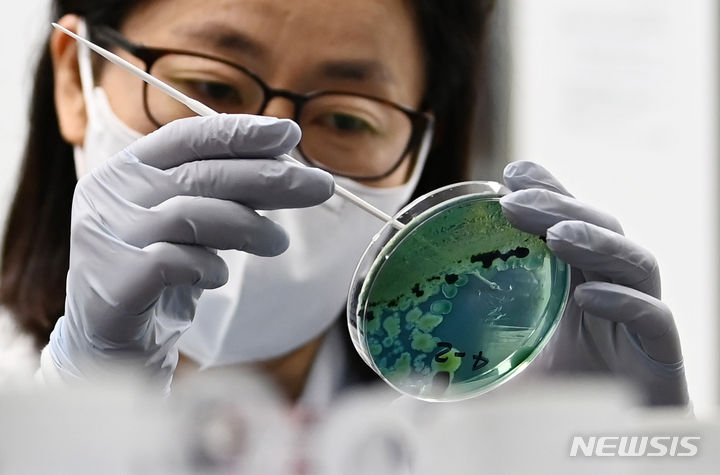

올해 첫 비브리오패혈증 검출
[수원=뉴시스] 김종택 기자 = 경기도 서해연안에서 올해 첫 비브리오패혈증균이 검출되자 22일 경기도 수원시 권선구 경기도보건환경연구원에서 연구원들이 채수한 바닷물을 배양작업하고 있다.
비브리오패혈증은 해수 온도가 18도 이상 상승하는 4~6월에 환자가 발생하기 시작, 8~9월에 집중적으로 발생한다. 오염된 해산물을 날것으로 섭취하거나 오염된 바닷물이 상처 난 피부와 접촉할 때 감염된다. 2024.05.22. [email protected]
Copyright © NEWSIS.COM, 무단 전재 및 재배포 금지